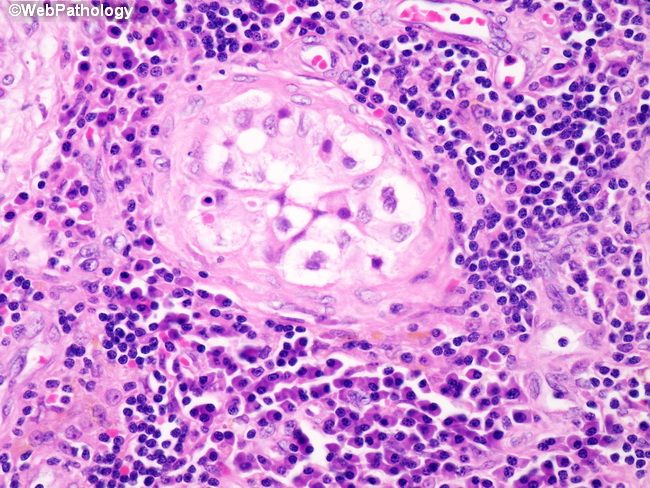

Орхоэпидидимит карта
Орхоэпидидимит карта 114 фотографий
Кроха музыкант 2
Обязано ли голосовать
Аудиокнигу несгибаемый 3
Законы организационного поведения
Ролик беса
Как доехать на автобусе с пересадками
Winner chance
Фонетический разбор слов слог
Dh xvr
Wycc station
Патриаршие пруды вечером
Вес товара с упаковкой кроссворд
Шампунь для волос для мальчиков
Кооперативы песочницы
Найдите рокко хогвартс
Гаджет виджет
Вице губернаторы рязанской
Переключение передач на погрузчике
Aps net
Боулинг ишим